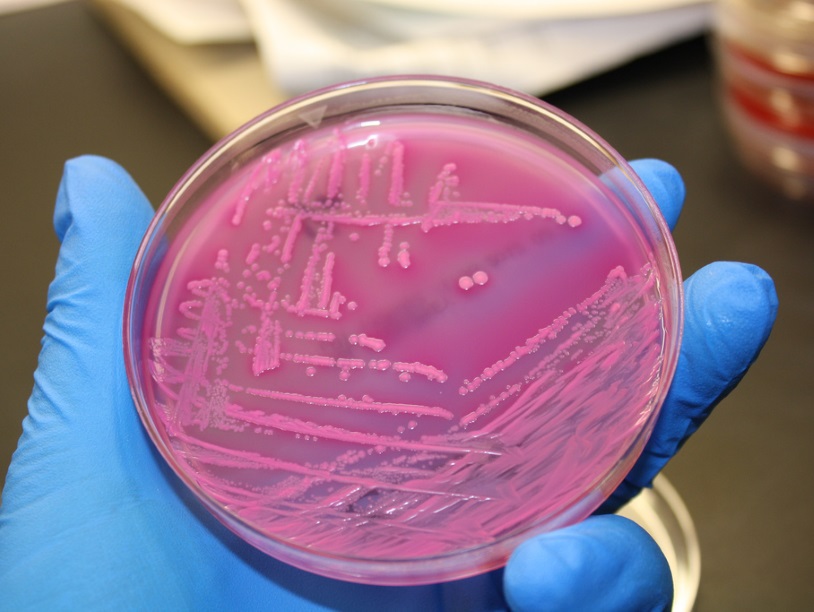

Коммуникация бактерий как лекарство от рака
Ученые из Университета Миссури обнаружили, что вещество, которое бактерии используют для общения друг с другом, помогает остановить распространение и рост раковых клеток и даже вызывает их смерть.
Хотя онкологические заболевания сами по себе довольно опасны, все же главную опасность в них представляет метастазирование. Спустя какое-то время после начала роста злокачественная опухоль прорастет в окружающие ткани и через нее прорастают кровеносные и лимфатические сосуды. По этим сосудам могут отправиться в путешествие по организму отделяющиеся от опухоли клетки. Они могут прикрепляться на новом месте и начать там делиться, образуя метастазы. Опухоли, классифицируемые как доброкачественные, не метастазируют. Наличие метастаз сразу заметно снижает шансы на выздоровление и долгую жизнь – именно поэтому так важна ранняя диагностика онкологических заболеваний.
У опухолей поджелудочной железы один из самых плохих прогнозов. Они быстро растут, рано начинают метастазировать и плохо реагируют на обычные химиотерапевтические препараты. Поэтому для поиска новых перспективных препаратов авторы работы забрались довольно далеко, к бактериям.
Бактерии могут общаться между собой. Эволюционно они приобрели это свойство очень давно, и сейчас разные бактерии пользуются им для самых разных целей. Бактерии секретируют в окружающую среду вещество, которое улавливается бактериями того же вида (а иногда и другого). Это вещество попадает внутрь бактериальной клетки и запускает там синтез определенных белков, нужных для адекватной реакции на происходящее. В английской литературе такое общение у бактерий называется quorum sensing.
В первую очередь, коммуникация нужна бактериям, чтобы оценить, сколько их тут. Во-первых, один в поле не воин, во-вторых, если бактерий станет слишком много, то им будет нечего есть. Поэтому бактерии кишечной палочки E. coli совместно решают, должны ли они делиться. Бактерии условно патогенной синегнойной палочки предпочитают сидеть в организме человека тихо, пока их мало, чтобы иммунитет их не заметил. Вести себя как патогены они начинают, когда обнаружат, что их много. Впервые явление коммуникации между бактериями было открыто у бактерий Aliivibrio fischeri. Они могут свободно жить в воде как планктон, и тогда их плотность низка. А могу поселиться симбионтами в фотофоре (органе свечения) живущего возле Гавайев и острова Мидуэй кальмара Euprymna scolopes. Там бактерии находятся в очень высокой плотности – 1011 бактерий в миллилитре. Когда бактерии живут свободно в воде – они не светятся. Как только они оказываются в большом количестве в малом объеме – они начинают синтезировать светящийся белок.
Для борьбы с раковыми клетками авторы работы позаимствовали молекулу у синегнойной палочки. Подходящим кандидатом оказалась молекула O-DDHSL (N-3-oxo-dodecanoyl-L-homoserine lactone). Еще раньше стало известно, что это вещество может замедлять рост многих типов клеток млекопитающих и вызывать смерть некоторых из них. Например, была показана его эффективность против клеток опухоли молочной железы.
Исследования показали, что O-DDHSL снижает выживаемость клеток карциномы поджелудочной желез, замедляет их деление и инициирует среди них апоптоз – клеточное самоубийство. Все эти эффекты были гораздо слабее выражены в экспериментах со здоровыми клетками эпителия поджелудочной железы, но все-таки не полностью исчезли. Это, разумеется, может стать помехой при переходе к испытаниям на животных. Но, в любом случае, испытания на животных начнутся в ближайшее время, и, мы надеемся, покажут эффективность нового потенциального препарата.